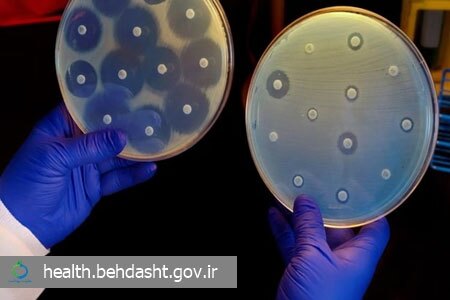

حکیم مهر: معاونت بهداشت وزارت بهداشت با اعلام شعار سال ۱۴۰۴ هفته جهانی آگاهی از مقاومت میکروبی با عنوان «اقدام فوری، حفاظت از امروز، تضمین آینده» عناوین روزشمار این هفته را اعلام کرد.
به گزارش حکیم مهر به نقل از وبدا، روزشمار هفته جهانی آگاهی از مقاومت میکروبی سال ۱۴۰۴ به شرح زیر است:
سهشنبه ۲۷ آبان: مسئولیت همگانی، مشارکت اجتماعی با رویکرد یکپارچه برای حفظ اثربخشی داروهای ضدمیکروبی
چهارشنبه ۲۸ آبان: آموزش، افزایش آگاهی و فرهنگسازی برای حفظ اثربخشی داروهای ضدمیکروبی
پنجشنبه ۲۹ آبان: رسالت رسانه برای حفظ اثربخشی داروهای ضدمیکروبی
جمعه ۳۰ آبان: پژوهش و فناوری برای حفظ اثربخشی داروهای ضدمیکروبی
شنبه ۱ آذر: ارائه مسئولانه خدمات سلامت و مدیریت مصرف برای حفظ اثربخشی داروهای ضدمیکروبی
یکشنبه ۲ آذر: دامپزشکی، مصرف مسئولانه برای حفظ اثربخشی داروهای ضدمیکروبی
دوشنبه ۳ آذر: محیط زیست و مدیریت پسماند برای حفظ اثربخشی داروهای ضدمیکروبی
مقاومت میکروبی زمانی رخ میدهد که یک داروی مؤثر بر میکروب، به دلیل تغییرات ایجادشده در آن میکروارگانیسم، دیگر توانایی اثرگذاری گذشته را نداشته باشد. این پدیده یک تهدید جدی برای سلامت بشر به شمار میرود، زیرا با بروز مقاومت، داروهای رایج اثربخشی خود را از دست میدهند و درمان بیماریها دشوارتر میشود.
هفته جهانی آگاهی از مقاومت میکروبی، فرصتی برای تاکید بر ضرورت اقدام فوری و همکاری بینبخشی برای پیشگیری از گسترش این پدیده و حفاظت از آینده درمانهای مؤثر است.